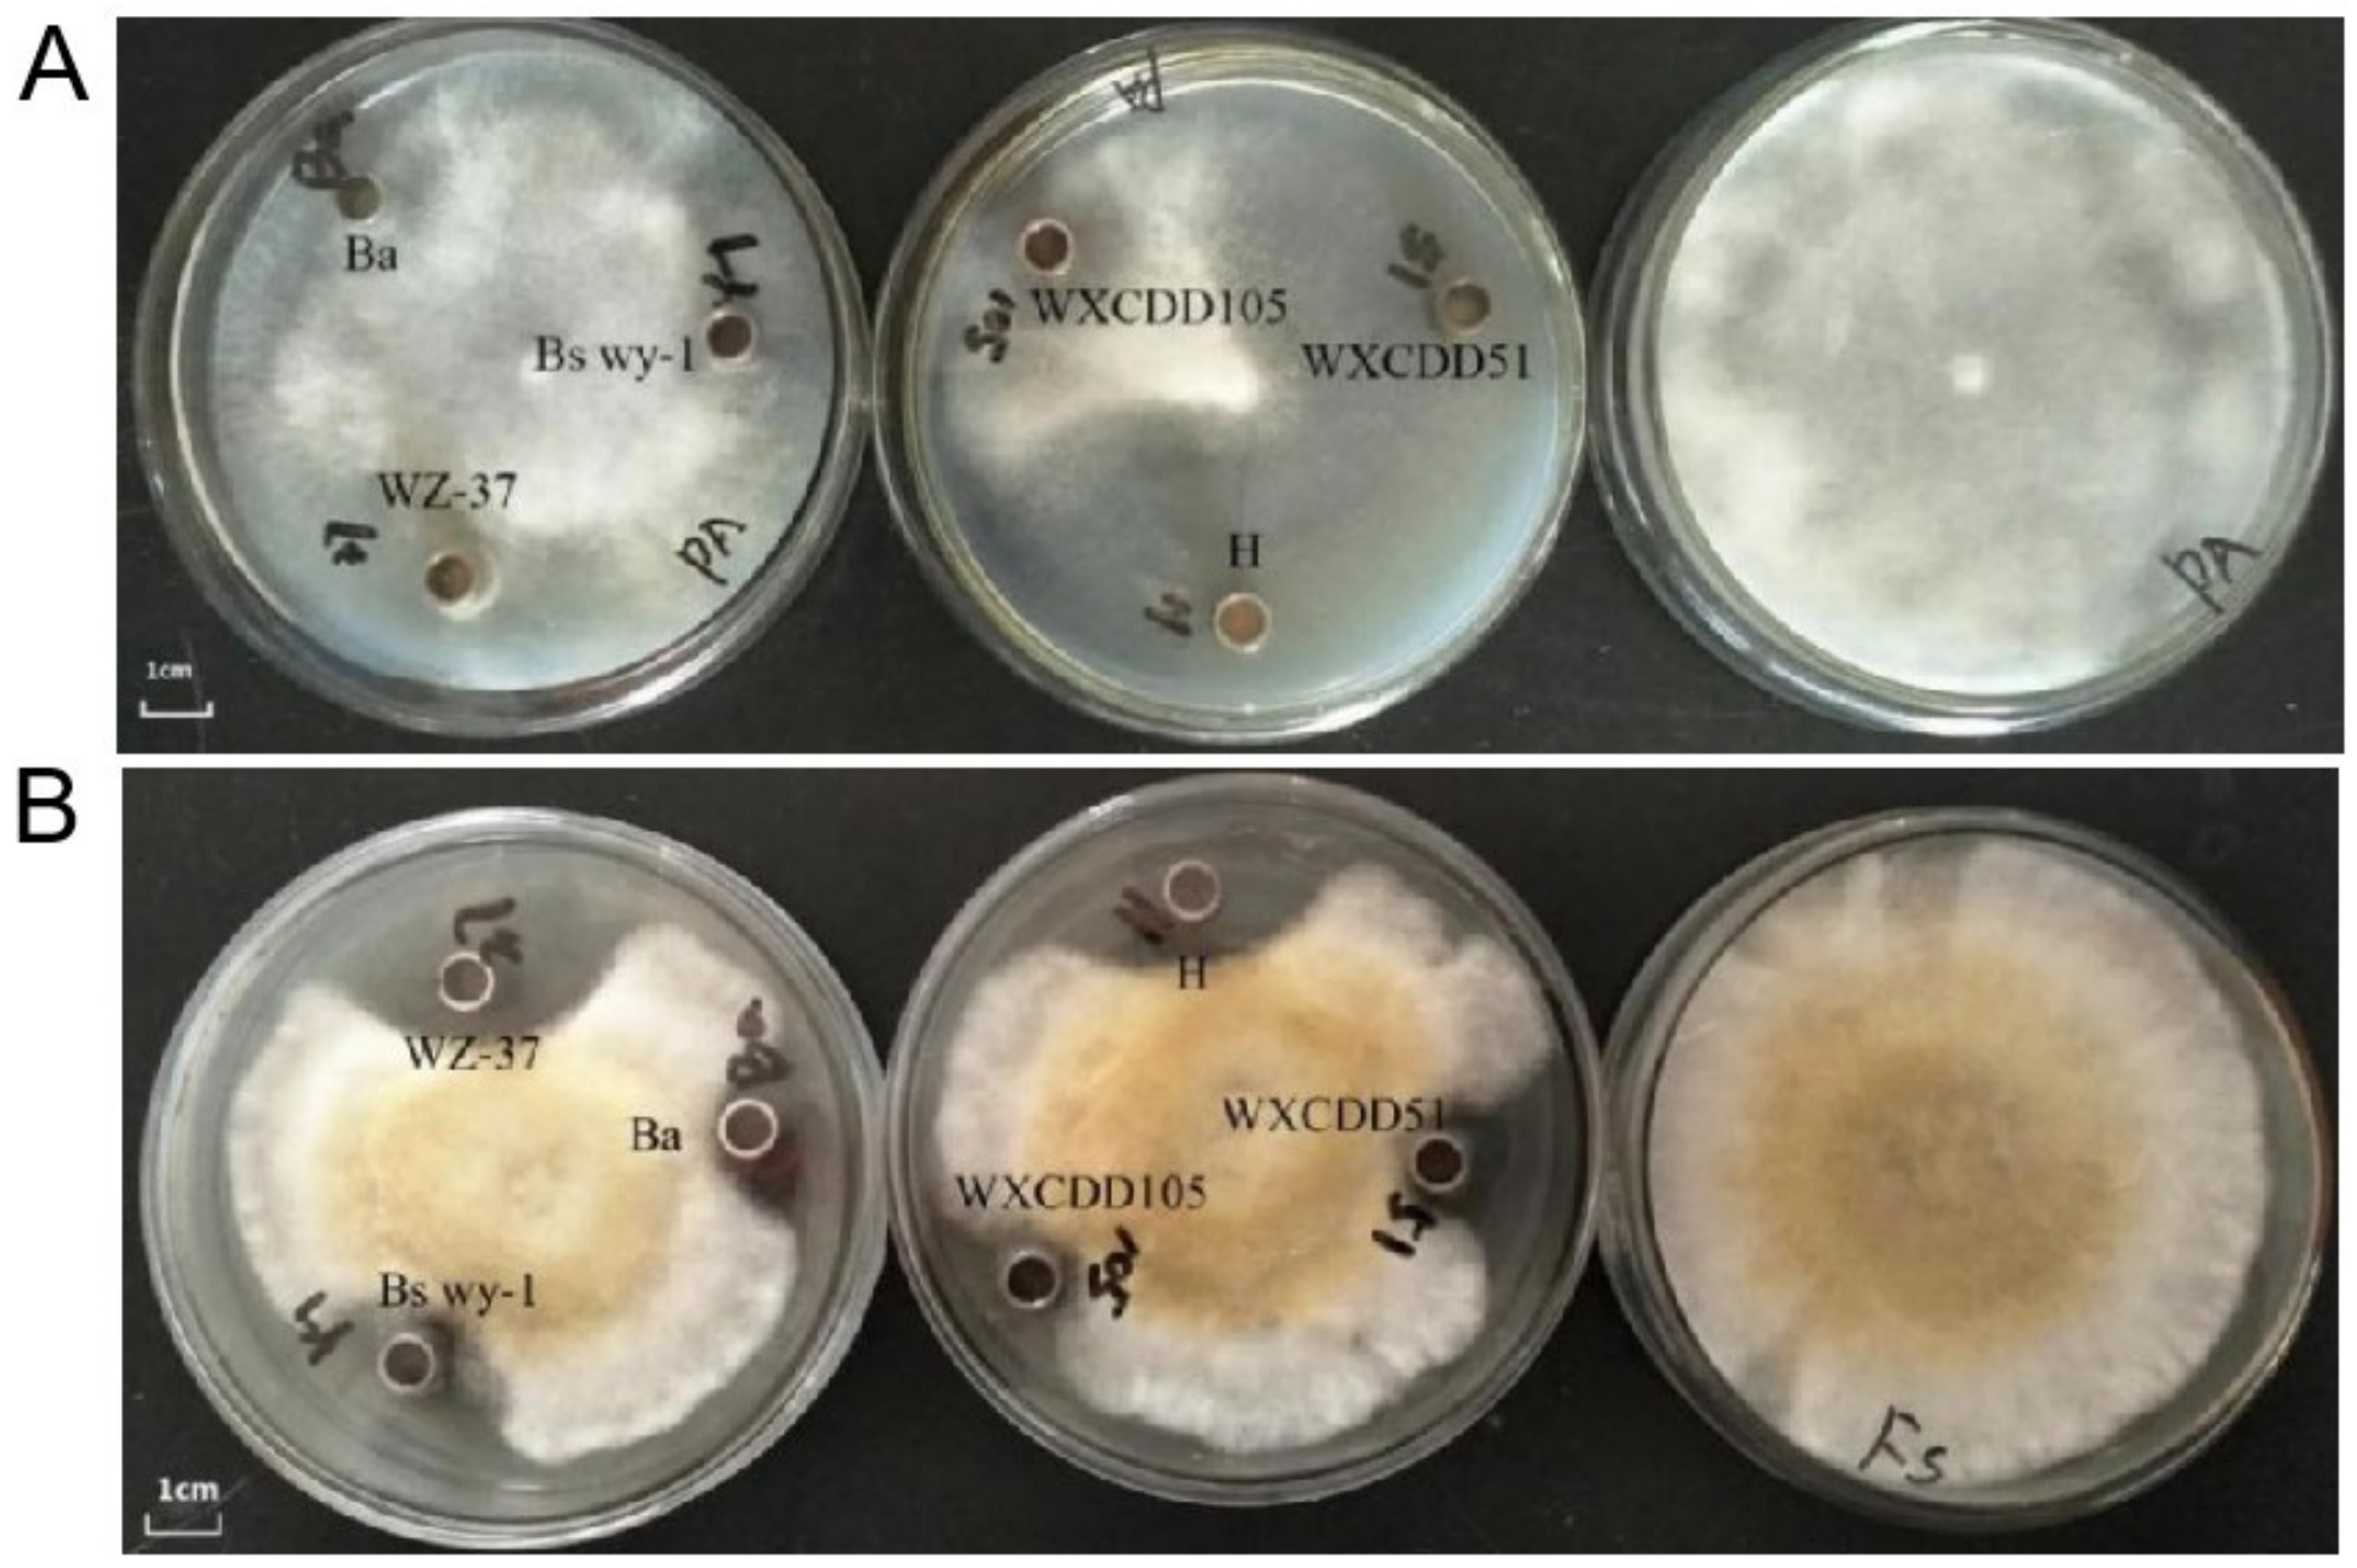

Study on the Preparation and Effect of Tomato Seedling Disease Biocontrol Compound Seed-Coating Agent
Abstract
1. Introduction
2. Materials and Methods
2.1. Experimental Strains and Plant Materials
2.2. Inhibitory Effect of Biocontrol Strains on PA-4 and FS-1
2.3. Germination-Promoting Effect of Five Isolates and Compound Bacteria on Tomato Seeds
2.4. Screening of Five Biocontrol Bacterial Composite Proportions
2.5. Effects of Different Auxiliaries on the Activity of Five Microorganisms
2.6. S-Compound Microbial Seed Coating Formulation
2.7. Optimization of S-Compound Microbial Seed Coating Formulation
2.8. Growth Promotion of Tomato Seedlings by S-Composite Microbial Seed Coating
2.9. Control Effect of S-Composite Microbial Seed Coating on Tomato Damping-Off and Root Rot Diseases
3. Results
3.1. Inhibitory Effect of Five Biocontrol Bacteria on sPA-4 and FS-1
3.2. Growth-Promoting Effect of Five Biocontrol Bacteria on Tomato Seeds
3.3. Screening of the Ratio of Five Biocontrol Bacteria
3.4. Selection of S-Compound Microbial Seed-Coating Agent
3.5. Development of S-Compound Microbial Seed Coating Formulation
3.6. Optimization of S-Compound Microbial Seed Coating Formulation
3.7. Promoting Effect of S-Complex Microbial Seed Coating on Tomato Seedlings
3.8. Preventive Effect of S-Complex Microbial Seed Coating on Tomato Damping-Off and Root Rot Disease
3.9. S-Composite Microbial Seed-Coating Agent Shelf Life Testing
4. Discussion
5. Conclusions
- The five biocontrol bacteria promote the germination of tomato seeds and the growth of radicles. The combination of WZ-37, WXCDD105, WXCDD51, BS wy-1, and Ba in the ratio of 100:100:1:1 could increase the germination rate of seeds by 4.5% in 48 h.
- Five additives with little damage to microbial activity were selected, including gas-phase silica, bentonite, diatomite, gum arabic, and sodium lignosulfonate. The preliminary formula of seed-coating agent was determined by orthogonal tests, and the final additives of seed-coating agent were gas-phase silica, gum arabic, and sodium dodecylbenzene sulfonate.
- Upon addition of 33.3 μL GA3 to S-compound microbial seed-coating agent, the effect of improving seed germination rate was the most significant.
- S-compound microbial seed-coating agent had significant growth-promoting effects on tomato seeds and seedlings. Pot experiments proved that S-compound microbial seed coating had good preventive effect on tomato damping-off disease and root rot, which was better than commercial chemical pesticide carbendazim wettable powder.
Supplementary Materials
Author Contributions
Funding
Acknowledgments
Conflicts of Interest
References
- Veit, S.; Wörle, J.M.; Nürnberger, T.; Koch, W.; Seitz, H.U. A novel protein elicitor (PaNie) from Pythium aphanidermatum induces multiple defense responses in carrot, Arabidopsis, and tobacco. Plant Physiol. 2001, 127, 832–841. [Google Scholar] [CrossRef]
- De Corato, U.; Salimbeni, R.; De Pretis, A. Suppression of soil-borne pathogens in container media amended with on-farm composted agro-bioenergy wastes and residues under glasshouse condition. J. Plant Dis. Prot. 2018, 125, 1–14. [Google Scholar] [CrossRef]
- Halo Boshra, A.; Al-Yahyai, R.A.; Al-Sadi, A.M. Aspergillus terreus inhibits growth and induces morphological abnormalities in Pythium aphanidermatum and suppresses Pythium-induced damping-off of cucumber. Front. Microbiol. 2018, 9, 95. [Google Scholar] [CrossRef]
- Nefzi, A.; Ben Abdallah, R.A.; Jabnoun-Khiareddine, H.; Ammar, N.; Medimagh-Saïdana, S.; Haouala, R.; Daami-Remadi, M. Management of fusarium crown and root rot of tomato by Solanum linnaeanum L. extracts. Sci. Hortic. 2018, 238, 204–214. [Google Scholar] [CrossRef]
- Pye, M.F.; Dye, S.M.; Resende, R.S.; MacDonald, J.D.; Bostock, R.M. Abscisic acid as a dominant signal in tomato during salt stress predisposition to phytophthora root and crown rot. Front. Plant Sci. 2018, 9, 525. [Google Scholar] [CrossRef] [PubMed]
- Cao, S.; Yang, N.; Zhao, C.; Liu, J.; Han, C.; Wu, X. Diversity of Fusarium species associated with root rot of sugar beet in China. J. Gen. Plant Pathol. 2018, 84, 321–329. [Google Scholar] [CrossRef]
- Shcherbakova, L.A.; Nazarova, T.A.; Mikityuk, O.D.; Istomina, E.A.; Odintsova, T.I. An extract purified from the mycelium of a tomato wilt-controlling strain of Fusarium sambucinum can protect wheat against Fusarium and common root rots. Pathogens. 2018, 7, 61. [Google Scholar] [CrossRef]
- Chauhan, A.; Ranjan, A.; Jindal, T. Biological control agents for sustainable agriculture, safe water and soil health. In Paradigms in Pollution Prevention; Springer: Cham, Switzerland, 2018; pp. 71–83. [Google Scholar]
- Hernández, J.A.; Cazapal-Monteiro, C.F.; Arroyo, F.L.; Silva, M.I.; Palomero, A.M.; Paz-Silva, A.; Sánchez-Andrade, R.; Arias, M.S. Biological control of soil transmitted helminths (STHs) in a zoological park by using saprophytic fungi. Biol. Control 2018, 122, 24–30. [Google Scholar] [CrossRef]
- Saraoui, T.; Fall, P.A.; Leroi, F.; Antignac, J.P.; Chéreau, S.; Pilet, M.F. Inhibition mechanism of Listeria monocytogenes by a bioprotective bacteria Lactococcus piscium CNCM I-4031. Food Microbiol. 2016, 53, 70–78. [Google Scholar] [CrossRef] [PubMed]
- Rodriguez, M.A.; Cabrera, G.; Gozzo, F.C.; Eberlin, M.N.; Godeas, A. Clonostachys rosea BAFC3874 as a Sclerotinia sclerotiorum antagonist: Mechanisms involved and potential as a biocontrol agent. J. Appl. Microbiol. 2011, 110, 1177–1186. [Google Scholar] [CrossRef] [PubMed]
- Wang, Q.; Chen, X.; Chai, X.; Xue, D.; Zheng, W.; Shi, Y.; Wang, A. The involvement of jasmonic acid, ethylene and salicylic acid in the signaling pathway of Clonostachys rosea-induced resistance to gray mold disease in tomato. Phytopathology 2019, 109, 1102–1114. [Google Scholar] [CrossRef]
- Li, Y.; Guo, Q.; Li, Y.; Sun, Y.; Xue, Q.; Lai, H. Streptomyces pactum Act12 controls tomato yellow leaf curl virus disease and alters rhizosphere microbial communities. Biol. Fertil. Soils 2019, 55, 149–169. [Google Scholar] [CrossRef]
- Chen, Q.; Bai, S.; Zhang, T.; Duan, C.; Zhao, J.; Xue, Q.; Li, Y. Effects of seed-coating preparations of living streptomyces globisporus on plant growth promotion and disease control against verticillium wilt in cotton. Sustainability 2021, 13, 6001. [Google Scholar] [CrossRef]
- Elshafie, H.S.; Sakr, S.; Bufo, S.A.; Camele, I. An attempt of biocontrol the tomato-wilt disease caused by Verticillium dahliae using Burkholderia gladioli pv. agaricicola and its bioactive secondary metabolites. Int. J. Plant Biol. 2017, 8, 57–60. [Google Scholar] [CrossRef][Green Version]
- Camele, I.; Elshafie, H.S.; Caputo, L.; Sakr, S.H.; de Feo, V. Bacillus mojavensis: Biofilm formation and biochemical investigation of its bioactive metabolites. J. Biol. Res. 2019, 92, 39–45. [Google Scholar] [CrossRef]
- Takahashi, Y.; Nakashima, T. Actinomycetes, an inexhaustible source of naturally occurring antibiotics. Antibiotics 2018, 7, 45. [Google Scholar] [CrossRef]
- Hug, J.J.; Bader, C.D.; Remškar, M.; Cirnski, K.; Müller, R. Concepts and methods to access novel antibiotics from actinomycetes. Antibiotics 2018, 7, 44. [Google Scholar] [CrossRef]
- Braun, H.; Woitsch, L.; Hetzer, B.; Geisen, R.; Zange, B.; Schmidt-Heydt, M. Trichoderma harzianum: Inhibition of mycotoxin producing fungi and toxin biosynthesis at a transcriptional level. Int. J. Food Microbiol. 2018, 280, 10–16. [Google Scholar] [CrossRef]
- Uddin, M.N.; Uddin, N.; Muhammad, M. Effect of Trichoderma harzianum on tomato plant growth and its antagonistic activity against Phythium ultimum and Phytopthora capsici. Egypt. J. Biol. Pest Control 2018, 28, 32. [Google Scholar] [CrossRef]
- Elshafie, H.S.; Nuzzaci, M.; Logozzo, G.; Gioia, T.; Camele, I. Biological investigations on the role of hydrogel formulations containing bioactive natural agents against some common phytopathogens of Phaseolus vulgaris L. and seed germination. J. Biol. Res. 2020, 93, 114–122. [Google Scholar] [CrossRef]
- Holfus, C.M.; Rios, R.C.; Boyd, C.S.; Mata-González, R. Preemergent herbicide protection seed coating: A promising new restoration tool. Rangel. Ecol. Manag. 2021, 76, 95–99. [Google Scholar] [CrossRef]
- Honglu, X.; Guomei, X. Suspension property of gemini surfactant in seed coating agent. J. Dispers. Sci. Technol. 2008, 29, 496–501. [Google Scholar] [CrossRef]
- Liang, Y.-J.; Zhang, X.-Q.; Yang, L.; Liu, X.H.; Yang, L.T.; Li, Y.R. Impact of seed coating agents on single-bud seedcane germination and plant growth in commercial sugarcane cultivation. Sugar Tech 2018, 21, 1–5. [Google Scholar] [CrossRef]
- Qian, J.; Shi, C.; Wang, S.; Song, Y.; Fan, B.; Wu, X. Cloud-based system for rational use of pesticide to guarantee the source safety of traceable vegetables. Food Control 2018, 87, 192–202. [Google Scholar] [CrossRef]
- Li, Z. Evaluation of regulatory variation and theoretical health risk for pesticide maximum residue limits in food. J. Environ. Manag. 2018, 219, 153–167. [Google Scholar] [CrossRef]
- Zhang, S.M. Efficacy and mechanism of biological seed coating agent against soybean root rot disease caused by Fusarium oxysporum f. sp. vedolens. Soybean Sci. 2009, 28, 863–868. [Google Scholar]
- Kipngeno, P.; Losenge, T.; Maina, N.; Kahangi, E.; Juma, P. Efficacy of Bacillus subtilis and Trichoderma asperellum against Pythium aphanidermatum in tomatoes. Biol. Control 2015, 90, 92–95. [Google Scholar] [CrossRef]
- Elshahawy, I.E.; El-Mohamedy, R.S. Biological control of Pythium damping-off and root-rot diseases of tomato using Trichoderma isolates employed alone or in combination. J. Plant Pathol. 2019, 101, 597–608. [Google Scholar] [CrossRef]
- Huang, Y.; Xiao, L.; Li, F.; Xiao, M.; Lin, D.; Long, X.; Wu, Z. Microbial degradation of pesticide residues and an emphasis on the degradation of cypermethrin and 3-phenoxy benzoic acid: A review. Molecules 2018, 23, 2313. [Google Scholar] [CrossRef]
- Zeng, D.; Shi, Y. Preparation and application of a novel environmentally friendly organic seed coating for rice. J. Sci. Food Agric. 2009, 89, 2181–2185. [Google Scholar] [CrossRef]
- Qiu, Y.; Amirkhani, M.; Mayton, H.; Chen, Z.; Taylor, A.G. Biostimulant seed coating treatments to improve cover crop germination and seedling growth. Agronomy 2020, 10, 154. [Google Scholar] [CrossRef]
- Luo, W.; Liu, L.; Qi, G.; Yang, F.; Shi, X.; Zhao, X. Embedding Bacillus velezensis NH-1 in microcapsules for biocontrol of cucumber Fusarium wilt. Appl. Environ. Microbiol. 2019, 85, e03128-18. [Google Scholar] [CrossRef] [PubMed]
- Sumpavapol, P.; Tongyonk, L.; Tanasupawat, S.; Chokesajjawatee, N.; Luxananil, P.; Visessanguan, W. Bacillus siamensis sp. nov., isolated from salted crab (poo-khem) in Thailand. Int. J. Syst. Evol. Microbiol. 2010, 60, 2364–2370. [Google Scholar] [CrossRef]
- Huang, Y.; Zhang, X.; Xu, H.; Zhang, F.; Zhang, X.; Yan, Y.; He, L.; Liu, J. Isolation of lipopeptide antibiotics from Bacillus siamensis: A potential biocontrol agent for Fusarium graminearum. Can. J. Microbiol. 2022, 99, 1–9. [Google Scholar] [CrossRef] [PubMed]
- Duijff, B.J.; Meijer, J.W.; Bakker, P.A.; Schippers, B. Siderophore-mediated competition for iron and induced resistance in the suppression of fusarium wilt of carnation by fluorescent pseudomonas spp. Neth. J. Plant Pathol. 1993, 99, 277–289. [Google Scholar] [CrossRef]
- Zhao, L.-M.; Wang, Q.-M.; Zhang, D.-D.; Ma, G.-L. Cooperative protection of American ginseng seedlings by applying imidacloprid, fludioxonil and phoxim. J. Chin. Med. Mater. 2015, 38, 1349–1354. [Google Scholar]
- Kuchlan, P.; Kuchlan, M.K.; Ansari, M.M. Efficient application of Trichoderma viride on soybean [Glycine max (L.) Merrill] seed using thin layer polymer coating. Legume Res. 2019, 42, 260–264. [Google Scholar] [CrossRef]
- Atique, U.; Farooq, M.; Nawaz, A.; Iqbal, S.; Rehman, A. Optimizing the boron seed coating treatments for improving the germination and early seedling growth of fine grain rice. Int. J. Agric. Biol. 2012, 14, 453–456. [Google Scholar]
- Hara, Y. Improvement of rice seedling establishment on sulfateapplied submerged soil by seed coating with poorly soluble molybdenum compounds. Plant Prod. Sci. 2013, 16, 271–275. [Google Scholar] [CrossRef]
- Chandrika, K.S.V.; Poorna, P.R.D.; Godbole, V. Development of chitosan-PEG blended films using Trichoderma: Enhancement of antimicrobial activity and seed quality. Int. J. Biol. Macromol. 2019, 126, 282–290. [Google Scholar] [CrossRef]
- Kthiri, Z.; Jabeur, M.B.; Machraoui, M.; Gargouri, S.; Hiba, K.; Hamada, W. Coating seeds with Trichoderma strains promotes plant growth and enhance the systemic resistance against Fusarium crown rot in durum wheat. Egypt J. Biol. Pest Control 2020, 30, 1–10. [Google Scholar] [CrossRef]
- Atolani, O.; Adamu, N.; Oguntoye, O.S.; Zubair, M.F.; Fabiyi, O.A.; Oyegoke, R.A.; Adeyemi, O.S.; Areh, E.T.; Tarigha, D.E.; Kambizi, L.; et al. Chemical characterization, antioxidant, cytotoxicity, anti-toxoplasma gondii and antimicrobial potentials of the Citrus sinensis seed oil for sustainable cosmeceutical production. Heliyon 2020, 6, e03399. [Google Scholar] [CrossRef] [PubMed]
- Hosseini, H.; Hamgini, E.Y.; Jafari, S.M.; Bolourian, S. Improving the oxidative stability of sunflower seed kernels by edible biopolymeric coatings loaded with rosemary extract. J. Stored Prod. Res. 2020, 89, 101729. [Google Scholar] [CrossRef]
- Janani, B.; Alarjani, K.M.; Raju, L.L.; Thomas, A.M.; Das, A.; Khan, S.S. A potent multifunctional Ag/Co-polyvinylpyrrolidone nanocomposite for enhanced detection of Cr (III) from environmental samples and its photocatalytic and antibacterial applications. Spectrochim. Acta A 2020, 243, 118766. [Google Scholar] [CrossRef]
- Sánchez-Silva, L.; Rodríguez, J.F.; Sánchez, P. Influence of different suspension stabilizers on the preparation of Rubitherm RT31 microcapsules. Colloid Surf. A 2011, 390, 62–66. [Google Scholar] [CrossRef]
- Da Costa, C.M.; dos Santos, R.S.; Marini, N.; da Maia, L.C.; Vanier, N.L.; Elias, M.C.; de Oliveira, M.; Costa de Oliveira, A. Seed coating and rice grain stickiness. Trop. Plant Biol. 2020, 13, 225–235. [Google Scholar] [CrossRef]
- Pathak, V.; Ambrose, R.K. Starch-based biodegradable hydrogel as seed coating for corn to improve early growth under water shortage. J. Appl. Polym. Sci. 2020, 137, 48523. [Google Scholar] [CrossRef]
- Tu, L.; He, Y.; Shan, C.; Wu, Z. Preparation of microencapsulated Bacillus subtilis SL-13 seed coating agents and their effects on the growth of cotton seedlings. Biomed. Res. Int. 2016, 2016, 3251357. [Google Scholar] [CrossRef]
- Anastassiades, M.; Schwack, W. Analysis of carbendazim, benomyl, thiophanate methyl and 2,4-dichlorophenoxyacetic acid in fruits and vegetables after supercritical fluid extraction. J. Chromatogr. A 1998, 825, 45–54. [Google Scholar] [CrossRef]

| Biocontrol Strains | PA-4 (Pythium aphanidermatum) | FS-1 (Fusarium sp.) | |
|---|---|---|---|
| WZ-37 (Bacillus velezensis) | Dry weight of mycelium (g) | 0.015 ± 0.0002c | 0.000 ± 0.0000f |
| Inhibition rate (g) | 92.96% | 100.00% | |
| WXCDD105 (Bacillus subtilis) | Dry weight of mycelium (g) | 0.018 ± 0.0005b | 0.012 ± 0.0005d |
| Inhibition rate (g) | 91.55% | 96.67% | |
| WXCDD51 (Pseudomonas fluorescens) | Dry weight of mycelium (g) | 0.000 ± 0.0000f | 0.016 ± 0.0007c |
| Inhibition rate (g) | 100.00% | 95.54% | |
| Bs wy-1 (Bacillus subtilis) | Dry weight of mycelium (g) | 0.010 ± 0.0003e | 0.019 ± 0.0002b |
| Inhibition rate (g) | 91.08% | 94.71% | |
| Ba (Bacillus amyloliquefaciens) | Dry weight of mycelium (g) | 0.013 ± 0.0002d | 0.01 ± 0.0005e |
| Inhibition rate (g) | 93.90% | 97.21% | |
| H (bacterial mixture) | Dry weight of mycelium (g) | 0.000 ± 0.0000f | 0.000 ± 0.0000f |
| Inhibition rate (g) | 100.00% | 100.00% | |
| CK (sterile water) | Dry weight of mycelium (g) | 0.213 ± 0.0008a | 0.359 ± 0.0004a |
| Inhibition rate (g) | - | - |
| Treatment | Plant Height/cm | Stem Diameter/mm | Root Length/cm | Fresh Weight/g | Dry Weight/g |
|---|---|---|---|---|---|
| CK | 7.3 ± 0.70b | 1.42 ± 0.03b | 4.33 ± 0.23b | 1.20 ± 0.12c | 0.081 ± 0.01b |
| D | 7.43 ± 0.35b | 1.41 ± 0.13b | 5.10 ± 0.53ab | 1.51 ± 0.06b | 0.0903 ± 0.01b |
| S | 9.95 ± 0.73a | 1.88 ± 0.15a | 6.01 ± 0.28a | 2.71 ± 0.08a | 0.1727 ± 0.01a |
| Treatment | Disease Index/100% | Relative Control Effect/100% |
|---|---|---|
| CK | 52.38 ± 6.44a | |
| S | 8.07 ± 3.59c | 84.54 |
| D | 31.43 ± 7.42b | 40 |
Publisher’s Note: MDPI stays neutral with regard to jurisdictional claims in published maps and institutional affiliations. |
© 2022 by the authors. Licensee MDPI, Basel, Switzerland. This article is an open access article distributed under the terms and conditions of the Creative Commons Attribution (CC BY) license (https://creativecommons.org/licenses/by/4.0/).
Share and Cite
Zhang, Y.; Li, Y.; Liang, S.; Zheng, W.; Chen, X.; Liu, J.; Wang, A. Study on the Preparation and Effect of Tomato Seedling Disease Biocontrol Compound Seed-Coating Agent. Life 2022, 12, 849. https://doi.org/10.3390/life12060849
Zhang Y, Li Y, Liang S, Zheng W, Chen X, Liu J, Wang A. Study on the Preparation and Effect of Tomato Seedling Disease Biocontrol Compound Seed-Coating Agent. Life. 2022; 12(6):849. https://doi.org/10.3390/life12060849
Chicago/Turabian StyleZhang, Yao, Yingying Li, Sibo Liang, Wei Zheng, Xiuling Chen, Jiayin Liu, and Aoxue Wang. 2022. "Study on the Preparation and Effect of Tomato Seedling Disease Biocontrol Compound Seed-Coating Agent" Life 12, no. 6: 849. https://doi.org/10.3390/life12060849
APA StyleZhang, Y., Li, Y., Liang, S., Zheng, W., Chen, X., Liu, J., & Wang, A. (2022). Study on the Preparation and Effect of Tomato Seedling Disease Biocontrol Compound Seed-Coating Agent. Life, 12(6), 849. https://doi.org/10.3390/life12060849






